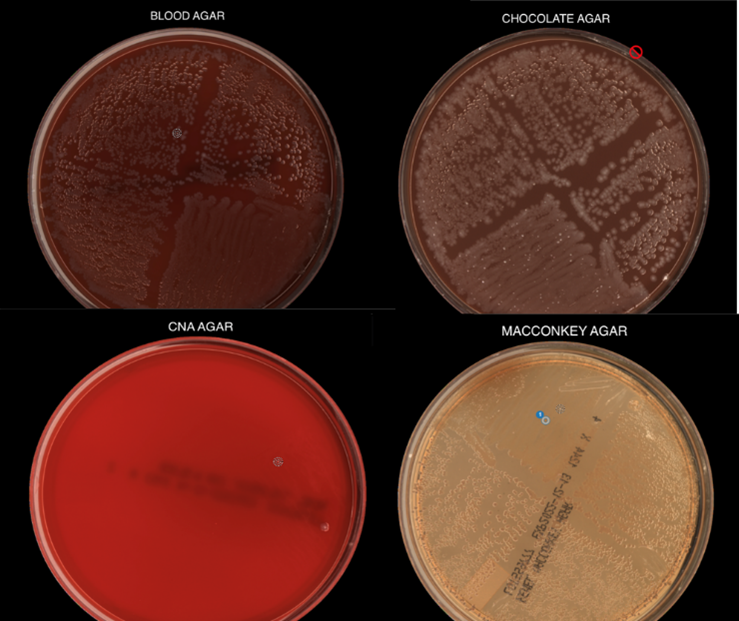
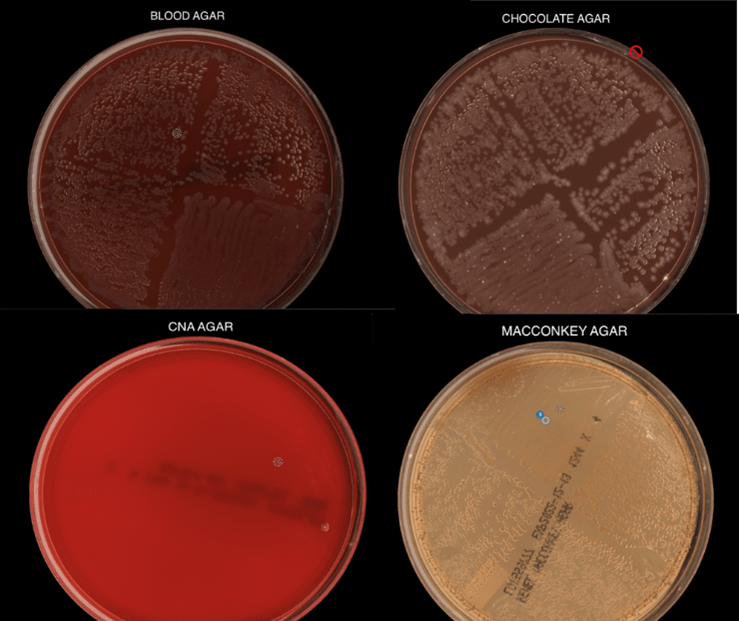

Microbiology Case: Lung nodules in a patient undergoing lung transplant evaluation
Case History
A 71-year-old male with a past medical history of severe interstitial lung disease (ILD) presented for lung transplant evaluation. His chest CT demonstrated findings consistent with his known diagnosis of ILD, along with a 3.6 cm focal nodular calcific density near the right costophrenic angle, and additional scattered calcified lung nodules measuring up to 3 mm. Sputum cultures were obtained to evaluate the CT findings.
Laboratory Identification
Routine bacterial, fungal, and AFB sputum testing was performed. No AFB were recovered, and a mixture of bacteria consistent with oral flora were found on blood, chocolate and MacConkey agars. The fungal culture grew a moderate amount of round, non-hyphenated yeast which were encapsulated, urease-positive and reacted with caffeic acid (Image 1A and 1B) consistent with Cryptococcus species. The organism was definitively identified as Cryptococcus gattii by MALDI-TOF mass spectrometry, which was subsequently confirmed by growth and the appearance of a deep blue color on Canavanine Glycine Bromothymol Blue (CGB) agar (Image 1C). The patient was prescribed daily fluconazole to take daily for 6 months, and underwent a successful bilateral transplant two months after treatment initiation.

Discussion
Cryptococci are important pathogens of both immunocompetent and immunocompromised hosts. While Cryptococcus neoformans causes most human cryptococcal disease, Cryptococcus gattii is also a clinically important cause of infections. Though genetically similar, these two species exhibit important differences with respect to ecological niche, pathogenesis, and epidemiology. Historically, trees (specifically eucalyptis) have been identified as environmental reservoirs of C. gattii, while C. neoformans is associated with pigeon guano.1 Cryptococcus neoformans has a worldwide distrubtion, while C. gattii is thought to be geographically restricted to Australia, Western Canada and the Pacific Northwest of the United States, although this has become less clear in recent years. Indeed, the patient in this case had not traveled to any of these locales; instead, he is from the southeastern United States, where the organism may be endemic.3
There is an established association between C. gattii and infections in immunocompetent hosts, and recent evidence points to genetic and immunological factors which predispose some individuals to C. gattii infection. Possible differences in clinical course and patient outcomes have been suggested to justify differentiation between C. gattii and C. neoformans in laboratory settings. Importantly, routine laboratory methods such as commercial biochemical identification systems, morphological observations, and cryptococcal antigen testing lack the discriminatory power to distinguish these species.2 By contrast, MALDI-TOF MS and molecular methods, including some molecular panels performed on positive blood culture bottles, are able to discriminate between C. gattii and C. neoformans. The use of glycine as a sole carbon and nitrogen source in the presence of canavanine allows biochemical differentiaton through the use of CGB agar. The degredtation of L-canavanine to ammonia in the presence of glycine by C. gattii raises the pH and results in associated color change, while C. neoformans remains a yellow or green color (Image 1C). While robust, this incubation can take up to five days resulting in prolonged turn around times.2
Cryptococal infection begins through inhalation of the organism into the lungs, where the yeast then can dissemisate to other anatomical sites. When compared to C. neoformans, C. gattii is less likely to present with central nervous system (CNS) involvement but exhibts a higher incidence of imaging abnormalities and mass lesions. In pulmonary settings, C. neoformans infections commonly present with infiltrates while C. gattii infections are nodular2 as seen in this case. Irrespective of the species involved, cryptococcal infections can be asymptomatic or classically present as a meningoencephalitis, chronic or acute pneumonia, or in a number of cutaneous manifestations. Fluconazole is the drug of choice for management of asymptomatic or mild to moderate pulmonary infections. Despite the removal of the infected lungs, it was determined that the patient should complete the entire six month course of fluconazole due to his immunosuppression post-transplant.
References
- Beardsley, J., Dao, A., Keighley, C., Garnham, K., Halliday, C., Chen, S. C.-A., and Sorrell, T.C. What’s New in Cryptococcus gattii: From Bench to Bedside and Beyond. J. Fungi. 2023; 9, 41:1-16.
- Butler-Wu, S. and Limaye, A.P. Guideline: A Quick Guide to the Significance and Laboratory Identification of Cryptococcus gattii. American Society for Microbiology. 2011. https://asm.org/Guideline/A-Quick-Guide-to-the-Significance-and-Laboratory-I Accessed: February 1st, 2023.
- Lockhart, S., Roe, C. C., and Engelthaler, D.M. Whole-Genome Analysis of Cryptococcus gattii, Southeastern United States. Emerg. Infect. Dis. 2016 Jun; 22(6): 1098-1101.

-Andrew Clark, PhD, D(ABMM) is an Assistant Professor at UT Southwestern Medical Center in the Department of Pathology, and Associate Director of the Clements University Hospital microbiology laboratory. He completed a CPEP-accredited postdoctoral fellowship in Medical and Public Health Microbiology at National Institutes of Health, and is interested in antimicrobial susceptibility and anaerobe pathophysiology.
-Francesca Lee, MD, is an associate professor in the Departments of Pathology and Internal Medicine (Infectious Diseases) at UT Southwestern Medical Center

-Clare McCormick-Baw, MD, PhD is an Assistant Professor of Clinical Microbiology at UT Southwestern in Dallas, Texas. She has a passion for teaching about laboratory medicine in general and the best uses of the microbiology lab in particular.